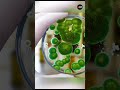
interesting story behind penicillin 🔥| SSP Shorts | #shorts  #ssp_sir

psycho
君はそっと微睡んだら 恍惚の階段へと
気高きこの瞬間から 蘇る野獣の性
深い溜め息の先で 哀の愛の一撃を
永遠に君を 奪い去る為に
渇き飢えてる唇の 奥に光る牙を剥いて
純血を吸い尽くしたら 恍惚へと深く刺して
神聖なるこの儀式で 混ざり合う遺伝子液
喘ぐ粘膜に染みる 哀の愛の一撃を
永遠に君を 奪い去る為に
今宵 さらなる 奇跡の高みへ はれて 暴かれた
生の極みへ
果てしなく 命の光を放て
限りある 時を赤く染めて
残酷な ナイフが心に刻む
傷口に 咲いた夢を開け
指先を研ぎ澄まして 首筋に殺意の愛撫
君はそっと微睡んだら 恍惚の階段へと
気高きこの瞬間から 蘇る野獣の性
深い溜め息の先で 哀の愛の一撃を
永遠に君を 奪い去る為に
今宵 さらなる 奇跡の高みへ はれて 暴かれた
生の極みへ
果てしなく 命の光を放て
限りある 時を赤く染めて
残酷な ナイフが心に刻む
傷口に 咲いた夢を開け
果てしなく 命の光を放て
限りある 時を赤く 染めて僕は
君を抱いたままで
RANKING
PENICILLINの人気動画歌詞ランキング





![Daryl Shares Merle's Drugs 💀 [4K] • The Walking Dead S2 E2 • #Shorts](https://i.ytimg.com/vi/7-enyx-Cgsc/default.jpg)